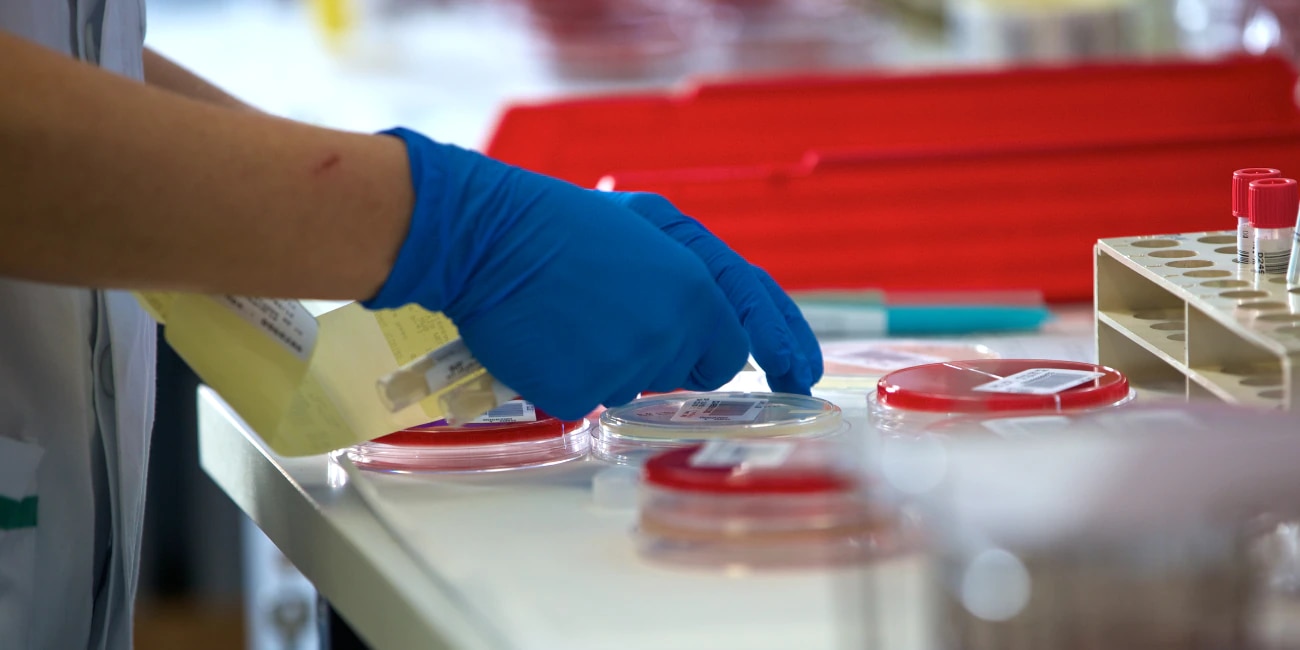

Aug 13, 2021
An estimated 30,100 central-line associated infections (CLABSIs) occur in intensive care units and on the floors of acute care facilities across the United States each year1.
Blood stream infections that are associated to catheters are called Catheter-Related Blood Stream Infection (CRBSI) and can be further divided into Central Line Associated Blood Stream Infection (CLABSI) and those related to peripheral lines such as PVC-BSIs.2.
Both of these types of blood stream infections (BSIs) can further be categorized as primary or secondary.
A primary BSI is a laboratory-confirmed infection that is not secondary to an infection at another site of the patient’s body1.
Secondary BSIs are “seeded” by an infection at a site that is not related to the insertion site of the infusion or vascular access device1.
Even though there are various causes for BSIs, we will focus on the causative events that are related to the insertion and maintenance of infusion and vascular access devices. These may include:
- – Improper hand hygiene on the part of the healthcare team2.
- – The incorrect use of the aseptic technique during insertion2.
- – Ignoring the early signs of infection which include2 (but are not limited to)
- Erythema
- Edema
- Pain
- Tenderness
- Drainage
- Skin breakdown at the insertion site
- Increased body temperature
- – Ineffective dressing changes2.
Types of microbes associated with blood stream infections
BSIs are caused by Gram-negative and Gram-positive bacteria3,4 as well as yeast. Amongst Gram-positive isolates, Staphylococcus aureus, Enterococccus species, and Streptococcus pneumoniae are amongst the most common. Coagulase-negative staphylococci (CNS) are also common Gram-positive bacteria that cause BSIs3.
One of the most common Gram-negative bacteria isolated from people with BSIs are Klebsiella species, Escherichia coli and Acinetobacter baumanii3.
Candida glabrata, Candida tropicalis, Candida albicans and Aspergillus niger4 are common fungal species that cause BSIs.
Effects of blood stream infections
CLABSIs may lead to prolonged hospital stays, increased cost to the patient and healthcare system, and increases the risk for sepsis and ultimately, death5.
In addition to these, over the last few decades, many microbes that cause BSIs have become increasingly antibiotic resistant6,7. Vancomycin Resistant Enterococcus (VRE)6 and Methicillin-Resistant Staphylococcus aureus (MRSA)7 are common antibiotic resistant BSIs. It is also no longer uncommon for clinicians to encounter multi-drug resistant BSI-causing microbes.
These added effects of BSIs buttress the need for healthcare teams to incorporate evidence-based practice to their daily routine so they can work to prevent these infections.
Preventing blood stream infections
The 2021 Infusion Therapy Standards of Practice (INS/SOP)2 is an excellent resource for preventing BSIs.
Using care bundles
The first practice recommendation under the INS/SOP Standard 50 (page s153) is for nurses and healthcare team members to “implement a care bundle in conjunction with a culture of safety and quality to reduce the risk of infection”.
A “care bundle” is a multifaceted approach to preventing BSIs from the moment the infusion or vascular device is inserted until its removal. A care bundle may consist of educational programs for nurses and everyone else involved in patient care, evidence-based hospital policy updates, visual aids, competency assessments, as well as ensuring the supplies to support catheter maintenance are available to staff8. A systematic review of studies published between January 2000 and December 2018 showed that care bundles can help reduce phlebitis and bloodstream infections9.
Assessing the site
The second practice recommendation under Standard 50 emphasizes assessing the vascular access site for the symptoms of BSIs we discussed earlier. When signs and symptoms of a BSI are present, nurses must notify a medical provider immediately so that the appropriate treatment can be initiated immediately2. In addition to the above, documenting what is happening at the site after assessment is crucial to detecting infections early.
Performing skin antisepsis
Performing skin antisepsis2 prior to placing a vascular access device as well as making it a part of routine care is another recommendation the INS/SOP provides. Standards 33, 42 and 50 of the INS/SOP cover these extensively.
Practical aspects of skin antisepsis may include:
- Evaluating the patient for any patient history of an allergy or sensitivity to skin antiseptics2,10,11.
- Washing the insertion site with soap and water2.
- Shaving excess hair at the insertion site if it is needed to help with applying dressing2. Note: Shaving is not always necessary and may in some instances increase the risk for infection12,13.
- Alcohol-based chlorhexidine is the preferred skin antiseptic recommended by the INS. Where there is no contraindication, nurses will need to perform skin antisepsis using this solution2.
- The applicator used to perform skin antisepsis must be a single-use sterile applicator and not a multiple use product such as a bottle of the antiseptic solution2,14.
Concluding thoughts
Bloodstream infections are costly. There is good news in the fight against BSIs. However, some BSIs may be preventable. It should be mandatory that healthcare teams receive training on evidence-based recommendations so that they can easily incorporate these into their daily practice.
The INS/SOP Standards 33, 42 and 50 provide excellent infection prevention practice recommendations that can reduce or prevent bloodstream infections.